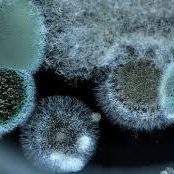

Leading the way
Expert Independent Indoor Environment Consultants
Projects Plus are an independent indoor environment management consultancy, specialising in damage assessment following disasters such as fires, floods, escapes of water or indoor environment related issues such as damp & mould. We work with home owners, insurers, loss adjusters, brokers, surveyors and business owners, supporting them with impartial and scientifically supported technical and practical advice for both commercial and residential properties. Projects Plus' independent consultancy services ensure properties get back to pre-incident condition, quickly and cost-effectively.

“Our home suffered a fire and after months of frustration with insurers Projects Plus helped establish a clear and full schedule for decontamination and drying the water damage from putting the fire out.”
Jackie, London, E8